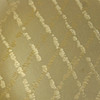

J. TOSTRUP. Servierteller, Sterlingsilber mit Emaille (7).
Diese Auktion ist beendet! Aber vielleicht gefallen Ihnen folgende Objekte?
Beschreibung
J. Tostrup (1806-1890), Satz aus 7 Serviertellern, Sterlingsilber mit Emaille, Norwegen, 1900er Jahre, jeder Teller hat ein geometrisches Design auf der Oberseite, an der Unterseite mit Stempel versehen: 'Sterling, J. Tostrup, Norway',
Maße großer Teller: Ø 16 cm, Gewicht ca.: 208 g.
Maße kleine Teller: Ø 8 cm, Gewicht je ca.: 33 g.
Zustandsbericht
Altersgemäßer Zustand, Gebrauchsspuren.
Folgerecht
Haben Sie etwas Ähnliches zu verkaufen? Lassen Sie Ihr Objekt kostenlos schätzen!
Gebotsabgabe
Lassen Sie Ihr Objekt kostenlos schätzen!
Beschreibung
J. Tostrup (1806-1890), Satz aus 7 Serviertellern, Sterlingsilber mit Emaille, Norwegen, 1900er Jahre, jeder Teller hat ein geometrisches Design auf der Oberseite, an der Unterseite mit Stempel versehen: 'Sterling, J. Tostrup, Norway',
Maße großer Teller: Ø 16 cm, Gewicht ca.: 208 g.
Maße kleine Teller: Ø 8 cm, Gewicht je ca.: 33 g.
Zustandsbericht
Altersgemäßer Zustand, Gebrauchsspuren.
Folgerecht
Haben Sie etwas Ähnliches zu verkaufen? Lassen Sie Ihr Objekt kostenlos schätzen!